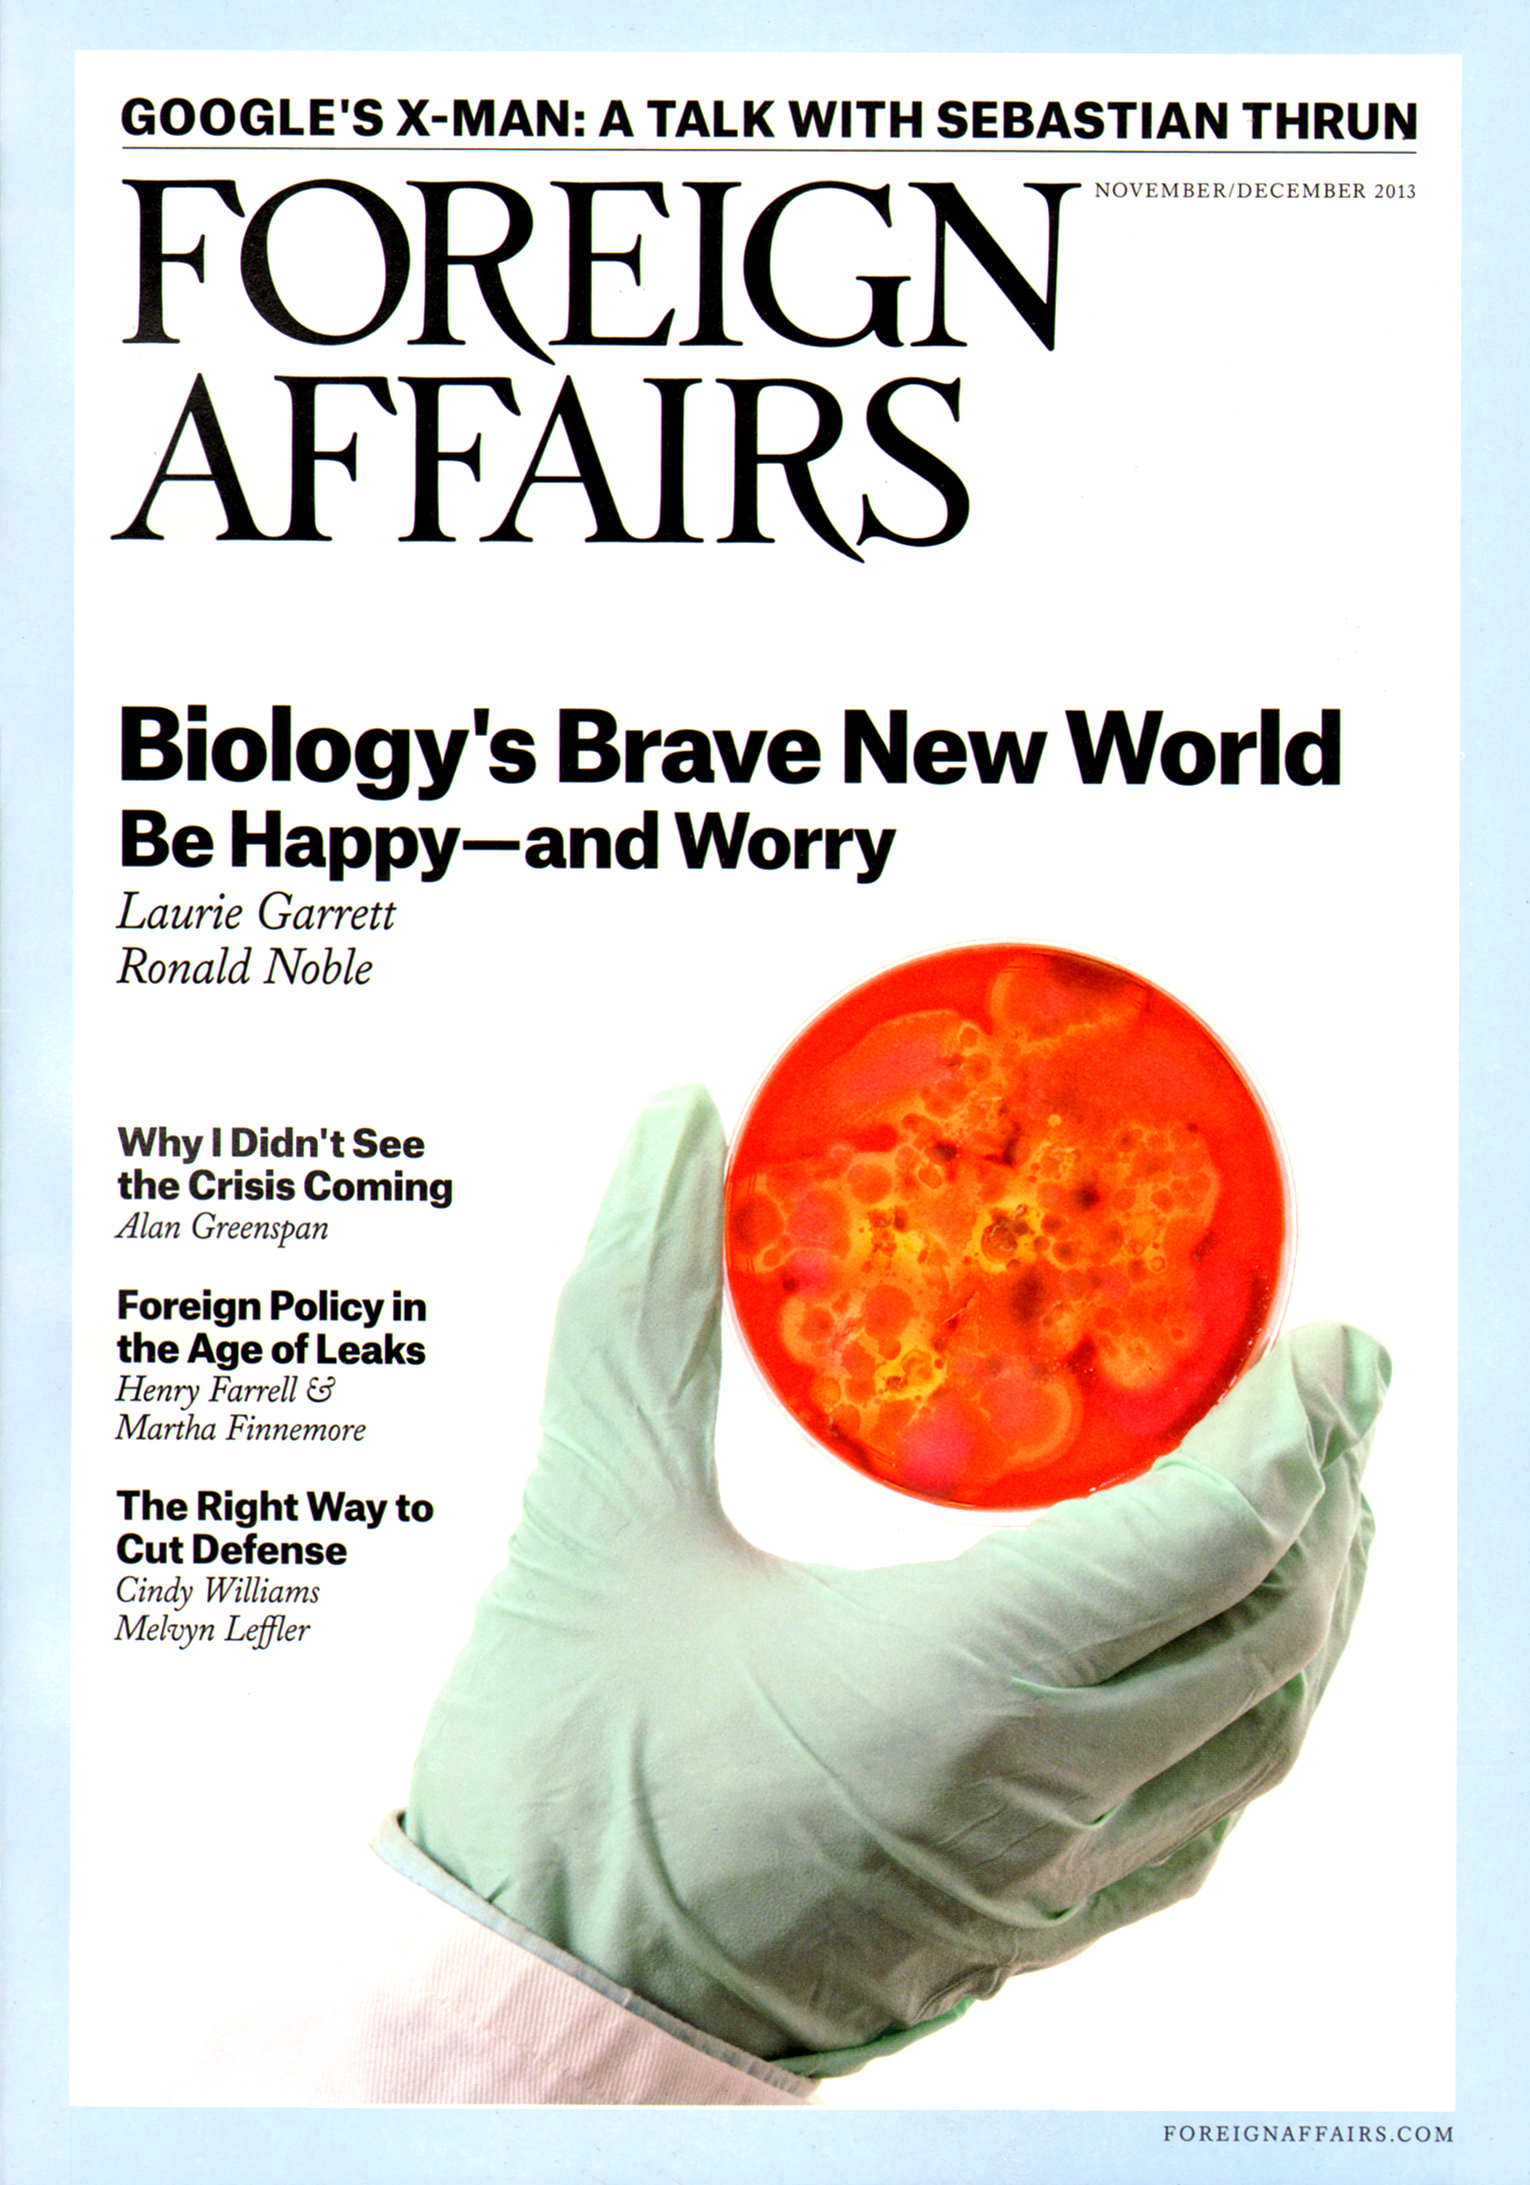
Foreign-Affairs November 01, 2013 Issue Cover

Quick Facts
- Categories: Humanities & Social Sciences, International, News & Politics
- Magazine-Agent.com Sales Rank:
- Published by: PWX Solutions
- Website: Foreign Affairs
- Customer Service Number: (800) 829-5539
Foreign Affairs Magazine
Since 1922, Foreign Affairs has been the leading publication on global current events, foreign policy, and international relations. It is published by the Council on Foreign Relations. Foreign Affairs is more than a magazine; it is the international forum of choice for the most important new ideas, analysis, and debate on the most significant issues in the world. Subscribers also receive online access to the current issue, a full year of back issues, and discounts on other digital products.
You May Also Like